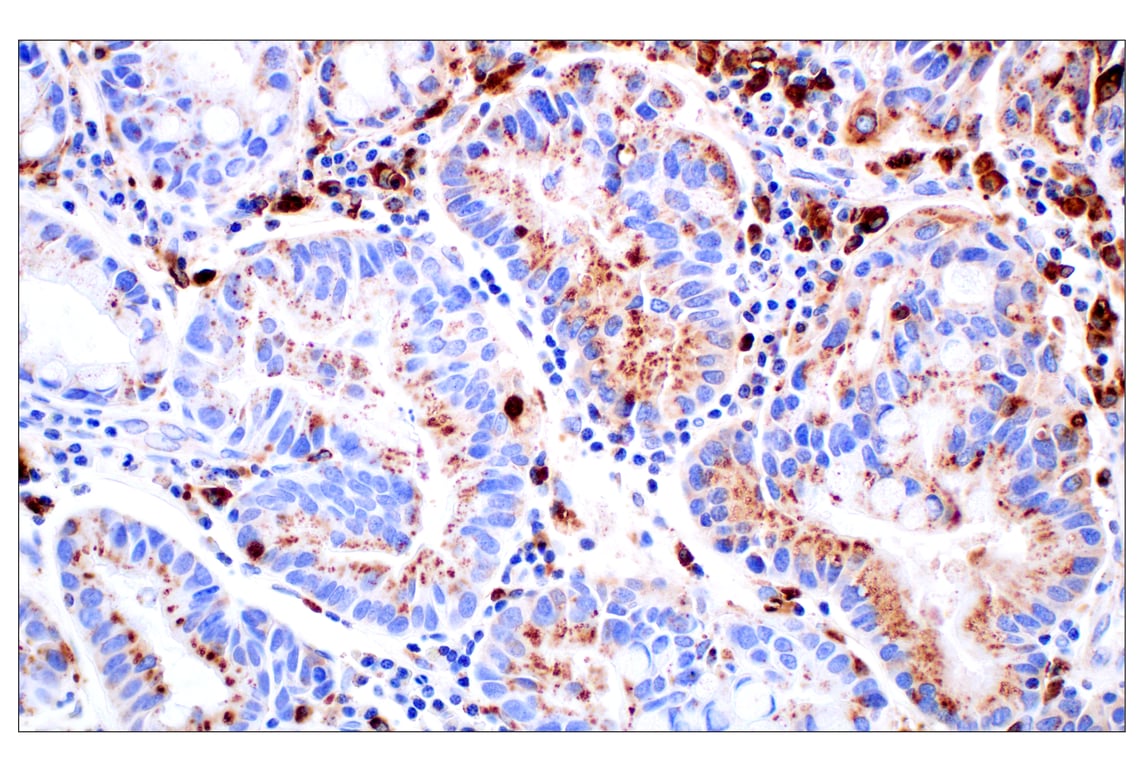
undefined Image 24: Genetics of Parkinson's Disease: Lysosomal Dysfunction Antibody Sampler Kit
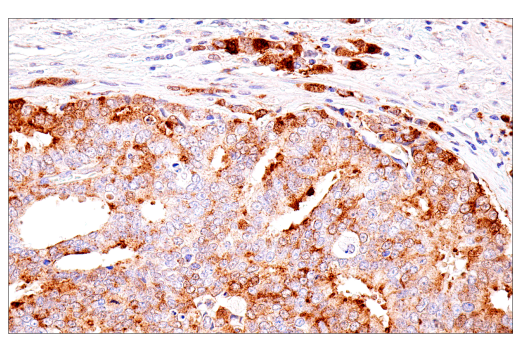
undefined Image 33: Genetics of Parkinson's Disease: Lysosomal Dysfunction Antibody Sampler Kit

Revision 2
#78646
Store at -20C
Genetics of Parkinson's Disease: Lysosomal Dysfunction Antibody Sampler Kit
1 Kit
(6 x 20 microliters)
877-616-CELL (2355)
877-678-TECH (8324)
3 Trask Lane | Danvers | Massachusetts | 01923 | USA
For Research Use Only. Not for Use in Diagnostic Procedures.
| Product Includes | Product # | Quantity | Mol. Wt | Isotype/Source |
|---|---|---|---|---|
| GCase/GBA (E2R1L) Rabbit Monoclonal Antibody | 88162 | 20 µl | 65 kDa | Rabbit IgG |
| Cathepsin D (E5V4H) Rabbit Monoclonal Antibody | 74089 | 20 µl | 46, 43, 28 kDa | Rabbit IgG |
| PARK9 Antibody | 5879 | 20 µl | 150 kDa | Rabbit |
| VPS35 (E6S4I) Rabbit Monoclonal Antibody | 81453 | 20 µl | 81 kDa | Rabbit IgG |
| LRRK2 (D18E12) Rabbit Monoclonal Antibody | 13046 | 20 µl | 290 kDa | Rabbit IgG |
| alpha-Synuclein (E4U2F) Rabbit Monoclonal Antibody | 51510 | 20 µl | 18 kDa | Rabbit IgG |
| Anti-rabbit IgG, HRP-linked Antibody | 7074 | 100 µl | Goat |
Please visit cellsignal.com for individual component applications, species cross-reactivity, dilutions, protocols, and additional product information.
Description
Storage
Background
α-Synuclein (α-Syn) is the main component of pathogenic Lewy bodies and neurites. Research studies have shown that mutations in the α-Synuclein gene are linked to PD (5). Neuronally generated pathogenic species of α-Syn accumulate within neuronal lysosomes and are released via SNARE-dependent lysosomal exocytosis. The released aggregates are non-membrane enveloped and seeding-competent, further contributing to PD pathology (6).
PARK9, also known as ATP13A2, is a member of the P-type ATPase superfamily. It localizes to the lysosomal membrane and is involved in the lysosomal degradation pathway, clearing α-Syn aggregates (7,8).
Cathepsin D (CTSD) is a ubiquitously expressed lysosomal aspartyl protease involved in normal protein degradation. Loss of CTSD leads to lysosomal dysfunction and accumulation of different cellular proteins implicated in neurodegenerative diseases, such as α-Syn (9).
Another gene genetically linked to PD is leucine-rich repeat kinase 2 (LRRK2), also known as PARK8 (10). Research studies have linked at least 20 mutations in LRRK2 to PD, with the G2019S mutation being the most prevalent (11). LRRK2 mutations alter lysosome morphology, distribution, pH, and degradative capacity in many distinct cell types, including fibroblasts, striatal neurons, primary neurons, and primary astrocytes (12).
Mutations in the vacuolar protein sorting-associated protein 35 (VPS35) gene, encoding a core component of the retromer complex, have recently emerged as a new cause of late-onset, autosomal dominant familial PD. A single missense mutation, Asp620Asn (D620N), has so far been unambiguously identified to cause PD (13). The VPS35 D620N mutation alters the expression of ~220 lysosomal proteins and stimulates recruitment of LRRK2 and phosphorylation of Rab proteins at the lysosome (14).
Background References
- Sidransky, E. and Lopez, G. (2012) Lancet Neurol 11, 986-98.
- Neumann, J. et al. (2009) Brain 132, 1783-94.
- Ho, M.W. et al. (1973) Biochem J 131, 173-6.
- Magalhaes, J. et al. (2016) Hum Mol Genet 25, 3432-3445.
- Goldberg, M.S. and Lansbury, P.T. (2000) Nat Cell Biol 2, E115-9.
- Xie, Y.X. et al. (2022) Nat Commun 13, 4918.
- Ramirez, A. et al. (2006) Nat Genet 38, 1184-91.
- Xiromerisiou, G. et al. (2010) Neurosurg Focus 28, E7.
- Faust, P.L. et al. (1985) Proc Natl Acad Sci USA 82, 4910-4.
- Moore, D.J. et al. (2005) Annu Rev Neurosci 28, 57-87.
- Mata, I.F. et al. (2006) Trends Neurosci 29, 286-93.
- Erb, M.L. and Moore, D.J. (2020) J Parkinsons Dis 10, 1271-1291.
- Williams, E.T. et al. (2017) J Parkinsons Dis 7, 219-233.
- Pal, P. et al. (2023) Sci Adv 9, eadj1205.
Trademarks and Patents
Cell Signaling Technology is a trademark of Cell Signaling Technology, Inc.
All other trademarks are the property of their respective owners. Visit cellsignal.com/trademarks for more information.
Limited Uses
Except as otherwise expressly agreed in a writing signed by a legally authorized representative of CST, the following terms apply to Products provided by CST, its affiliates or its distributors. Any Customer's terms and conditions that are in addition to, or different from, those contained herein, unless separately accepted in writing by a legally authorized representative of CST, are rejected and are of no force or effect.
Products are labeled with For Research Use Only or a similar labeling statement and have not been approved, cleared, or licensed by the FDA or other regulatory foreign or domestic entity, for any purpose. Customer shall not use any Product for any diagnostic or therapeutic purpose, or otherwise in any manner that conflicts with its labeling statement. Products sold or licensed by CST are provided for Customer as the end-user and solely for research and development uses. Any use of Product for diagnostic, prophylactic or therapeutic purposes, or any purchase of Product for resale (alone or as a component) or other commercial purpose, requires a separate license from CST. Customer shall (a) not sell, license, loan, donate or otherwise transfer or make available any Product to any third party, whether alone or in combination with other materials, or use the Products to manufacture any commercial products, (b) not copy, modify, reverse engineer, decompile, disassemble or otherwise attempt to discover the underlying structure or technology of the Products, or use the Products for the purpose of developing any products or services that would compete with CST products or services, (c) not alter or remove from the Products any trademarks, trade names, logos, patent or copyright notices or markings, (d) use the Products solely in accordance with CST Product Terms of Sale and any applicable documentation, and (e) comply with any license, terms of service or similar agreement with respect to any third party products or services used by Customer in connection with the Products.
Revision 2



Revision 2



Revision 2



Revision 2



Revision 2



Revision 2



Revision 2



Revision 2

Revision 2



Revision 2



Revision 2

Revision 2



Revision 2



Revision 2
Immunohistochemical analysis of paraffin-embedded mouse thymus using Cathepsin D (E5V4H) Rabbit mAb.


Immunohistochemical analysis of paraffin-embedded mouse testes using Cathepsin D (E5V4H) Rabbit mAb.

Revision 2



Revision 2



Revision 2


